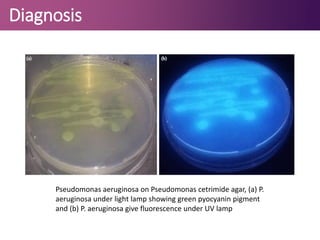
Diagnosis
Pseudomonas aeruginosa on Pseudomonas cetrimide agar, (a) P.
aeruginosa under light lamp showing green pyocyanin pigment
and (b) P. aeruginosa give fluorescence under UV lamp

Pseudomonas aeruginosa is a gram-negative bacterium associated with opportunistic infections, particularly in hospitalized patients due to its resistance to antibiotics and presence in moist environments. It can cause a variety of infections including pneumonia, skin infections, and bacteremia, with notable virulence factors like toxin A and exoenzyme S that inhibit protein synthesis in host cells. Diagnosis is typically through isolation and lab identification, and treatment may involve combination antibiotic therapies due to the bacterium's high antibiotic resistance.